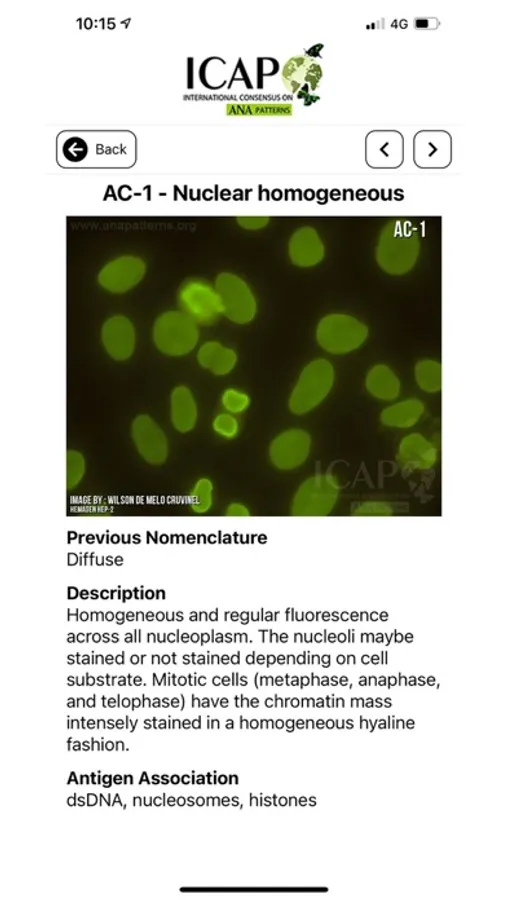

About ICAP Official App
Welcome to the official app for the International Consensus on Antinuclear Antibody (ANA) Patterns (ICAP). ICAP was initiated as a workshop aiming to thoroughly discuss and to promote consensus regarding the richness and nuances of morphological patterns observed in the indirect immunofluorescence assay on HEp-2 cells (HEp-2 IFA). The ICAP initiative was implemented at the 12th International Workshop on Autoantibodies and Autoimmunity (IWAA, São Paulo, Brazil) by members of the Autoantibody Standardization Committee (ASC), a subcommittee of the International Union of Immunological Societies (IUIS) Quality Assessment and Standardization Committee and affiliated with the Centers for Diseases Control and Prevention (CDC). The ICAP committee is operating as an ASC sub-committee.
ICAP Official App Screenshots
Tap to Rate: